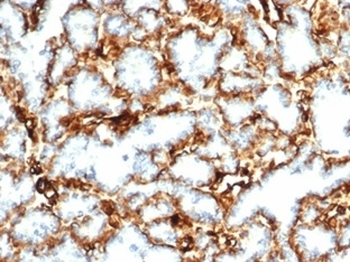
Recombinant Wilms Tumor 1 Antibody / WT1
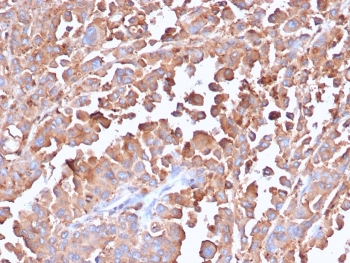
Recombinant Carcinoembryonic Antigen Antibody / CEA

You have no items in your shopping cart.
Search results for: 'antibody'
- Recombinant Topoisomerase II alpha Antibody / TOP2A [orb2637102]
IHC-P
Human, Mouse
Mouse
Recombinant
Unconjugated
100 μg - Recombinant EpCAM Antibody / Cytoplasmic domain [orb2637306]
IHC-P
Human
Rabbit
Recombinant
Unconjugated
100 μg - Recombinant Carcinoembryonic Antigen Antibody / CEA [orb2636680]
IHC-P
Human
Rabbit
Recombinant
Unconjugated
100 μg IHC-P
Human
Mouse
Recombinant
Unconjugated
100 μgIHC-P
Human
Mouse
Recombinant
Unconjugated
100 μg